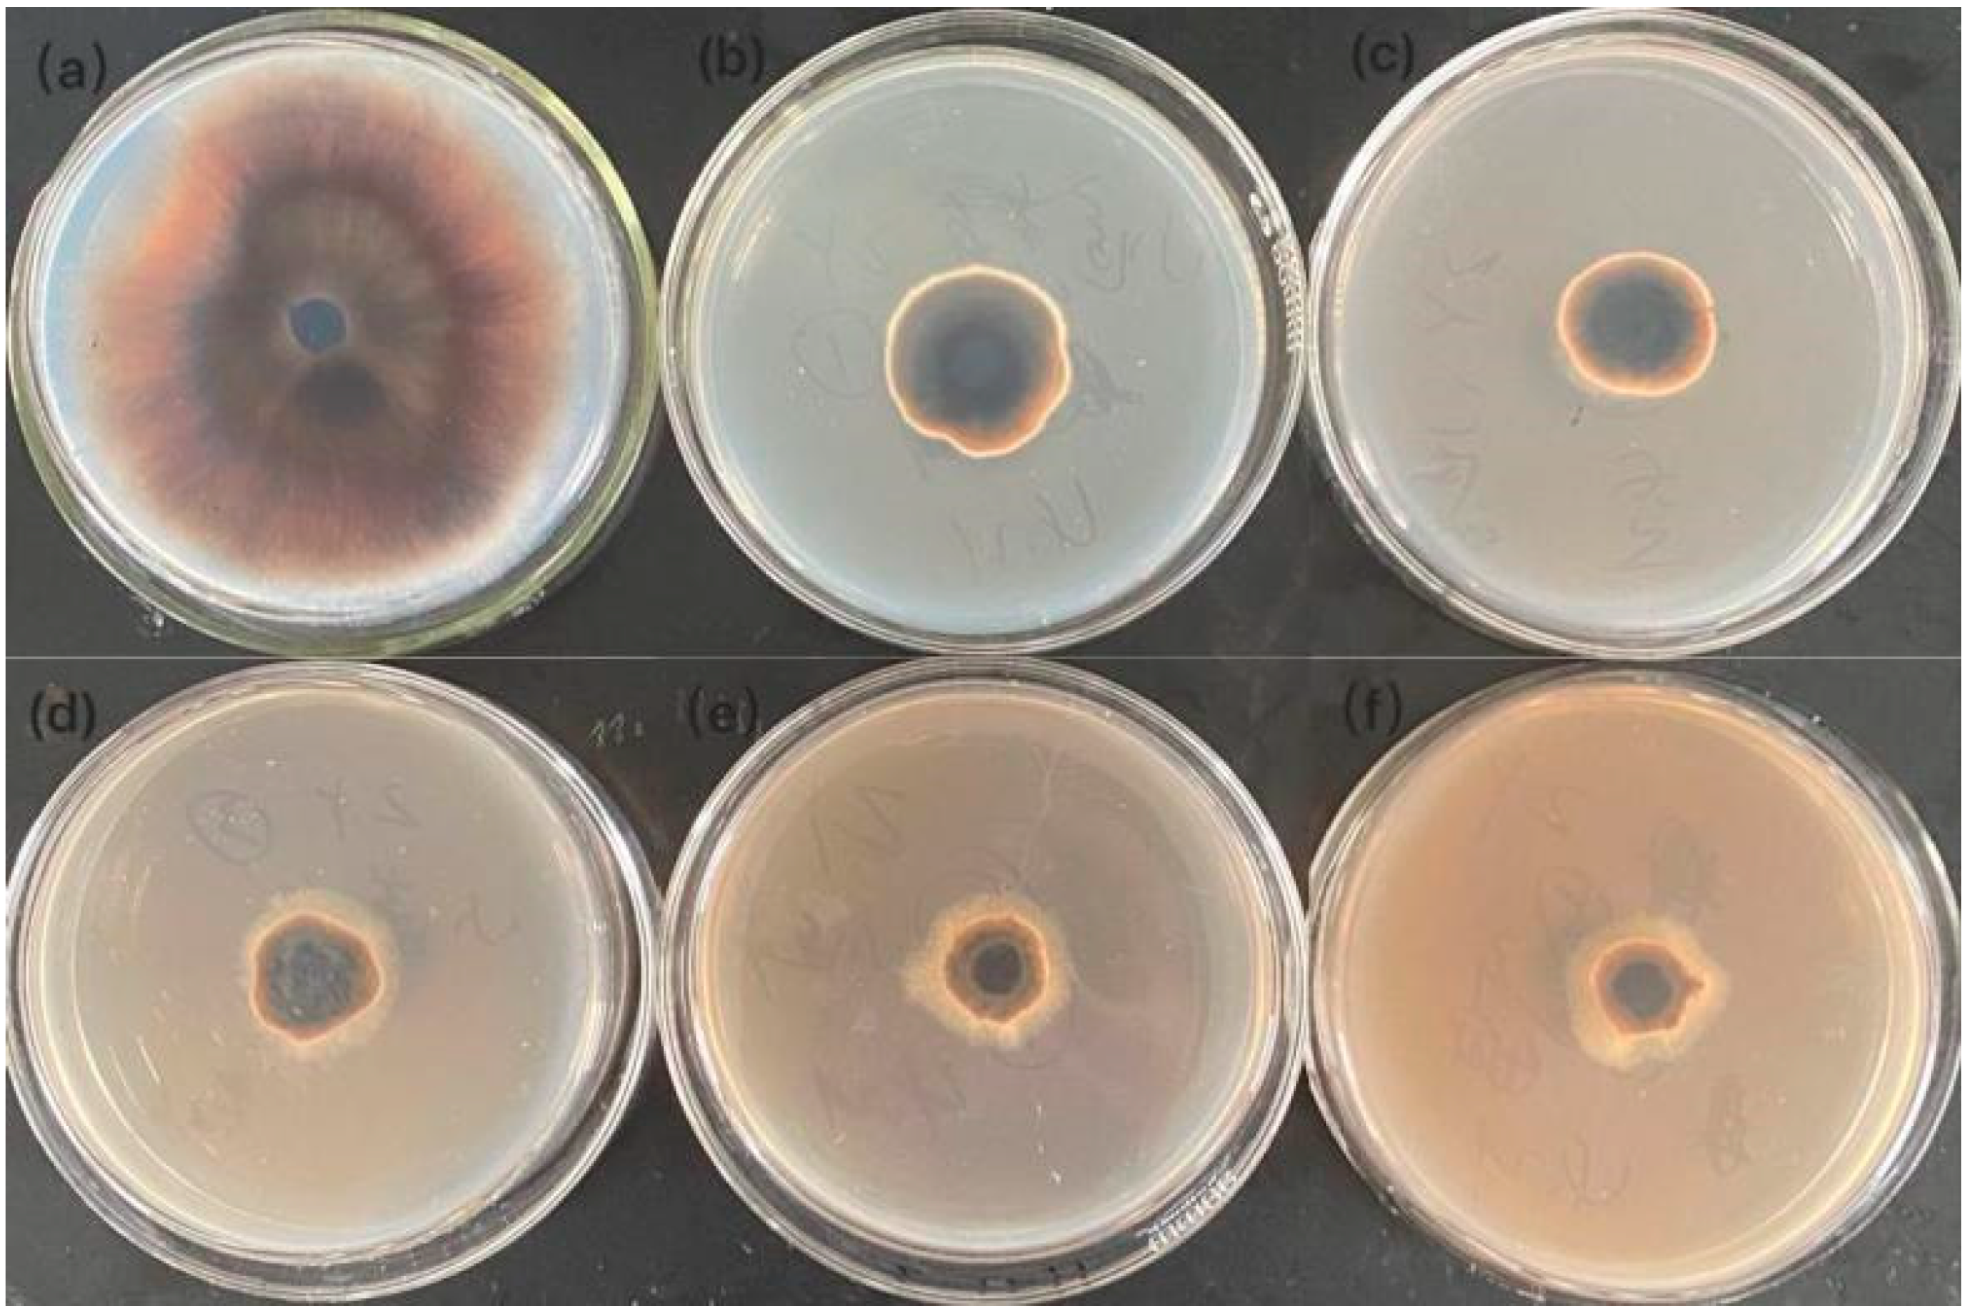
Crystals 11 01443 g005 Crystals 11 01443 g005
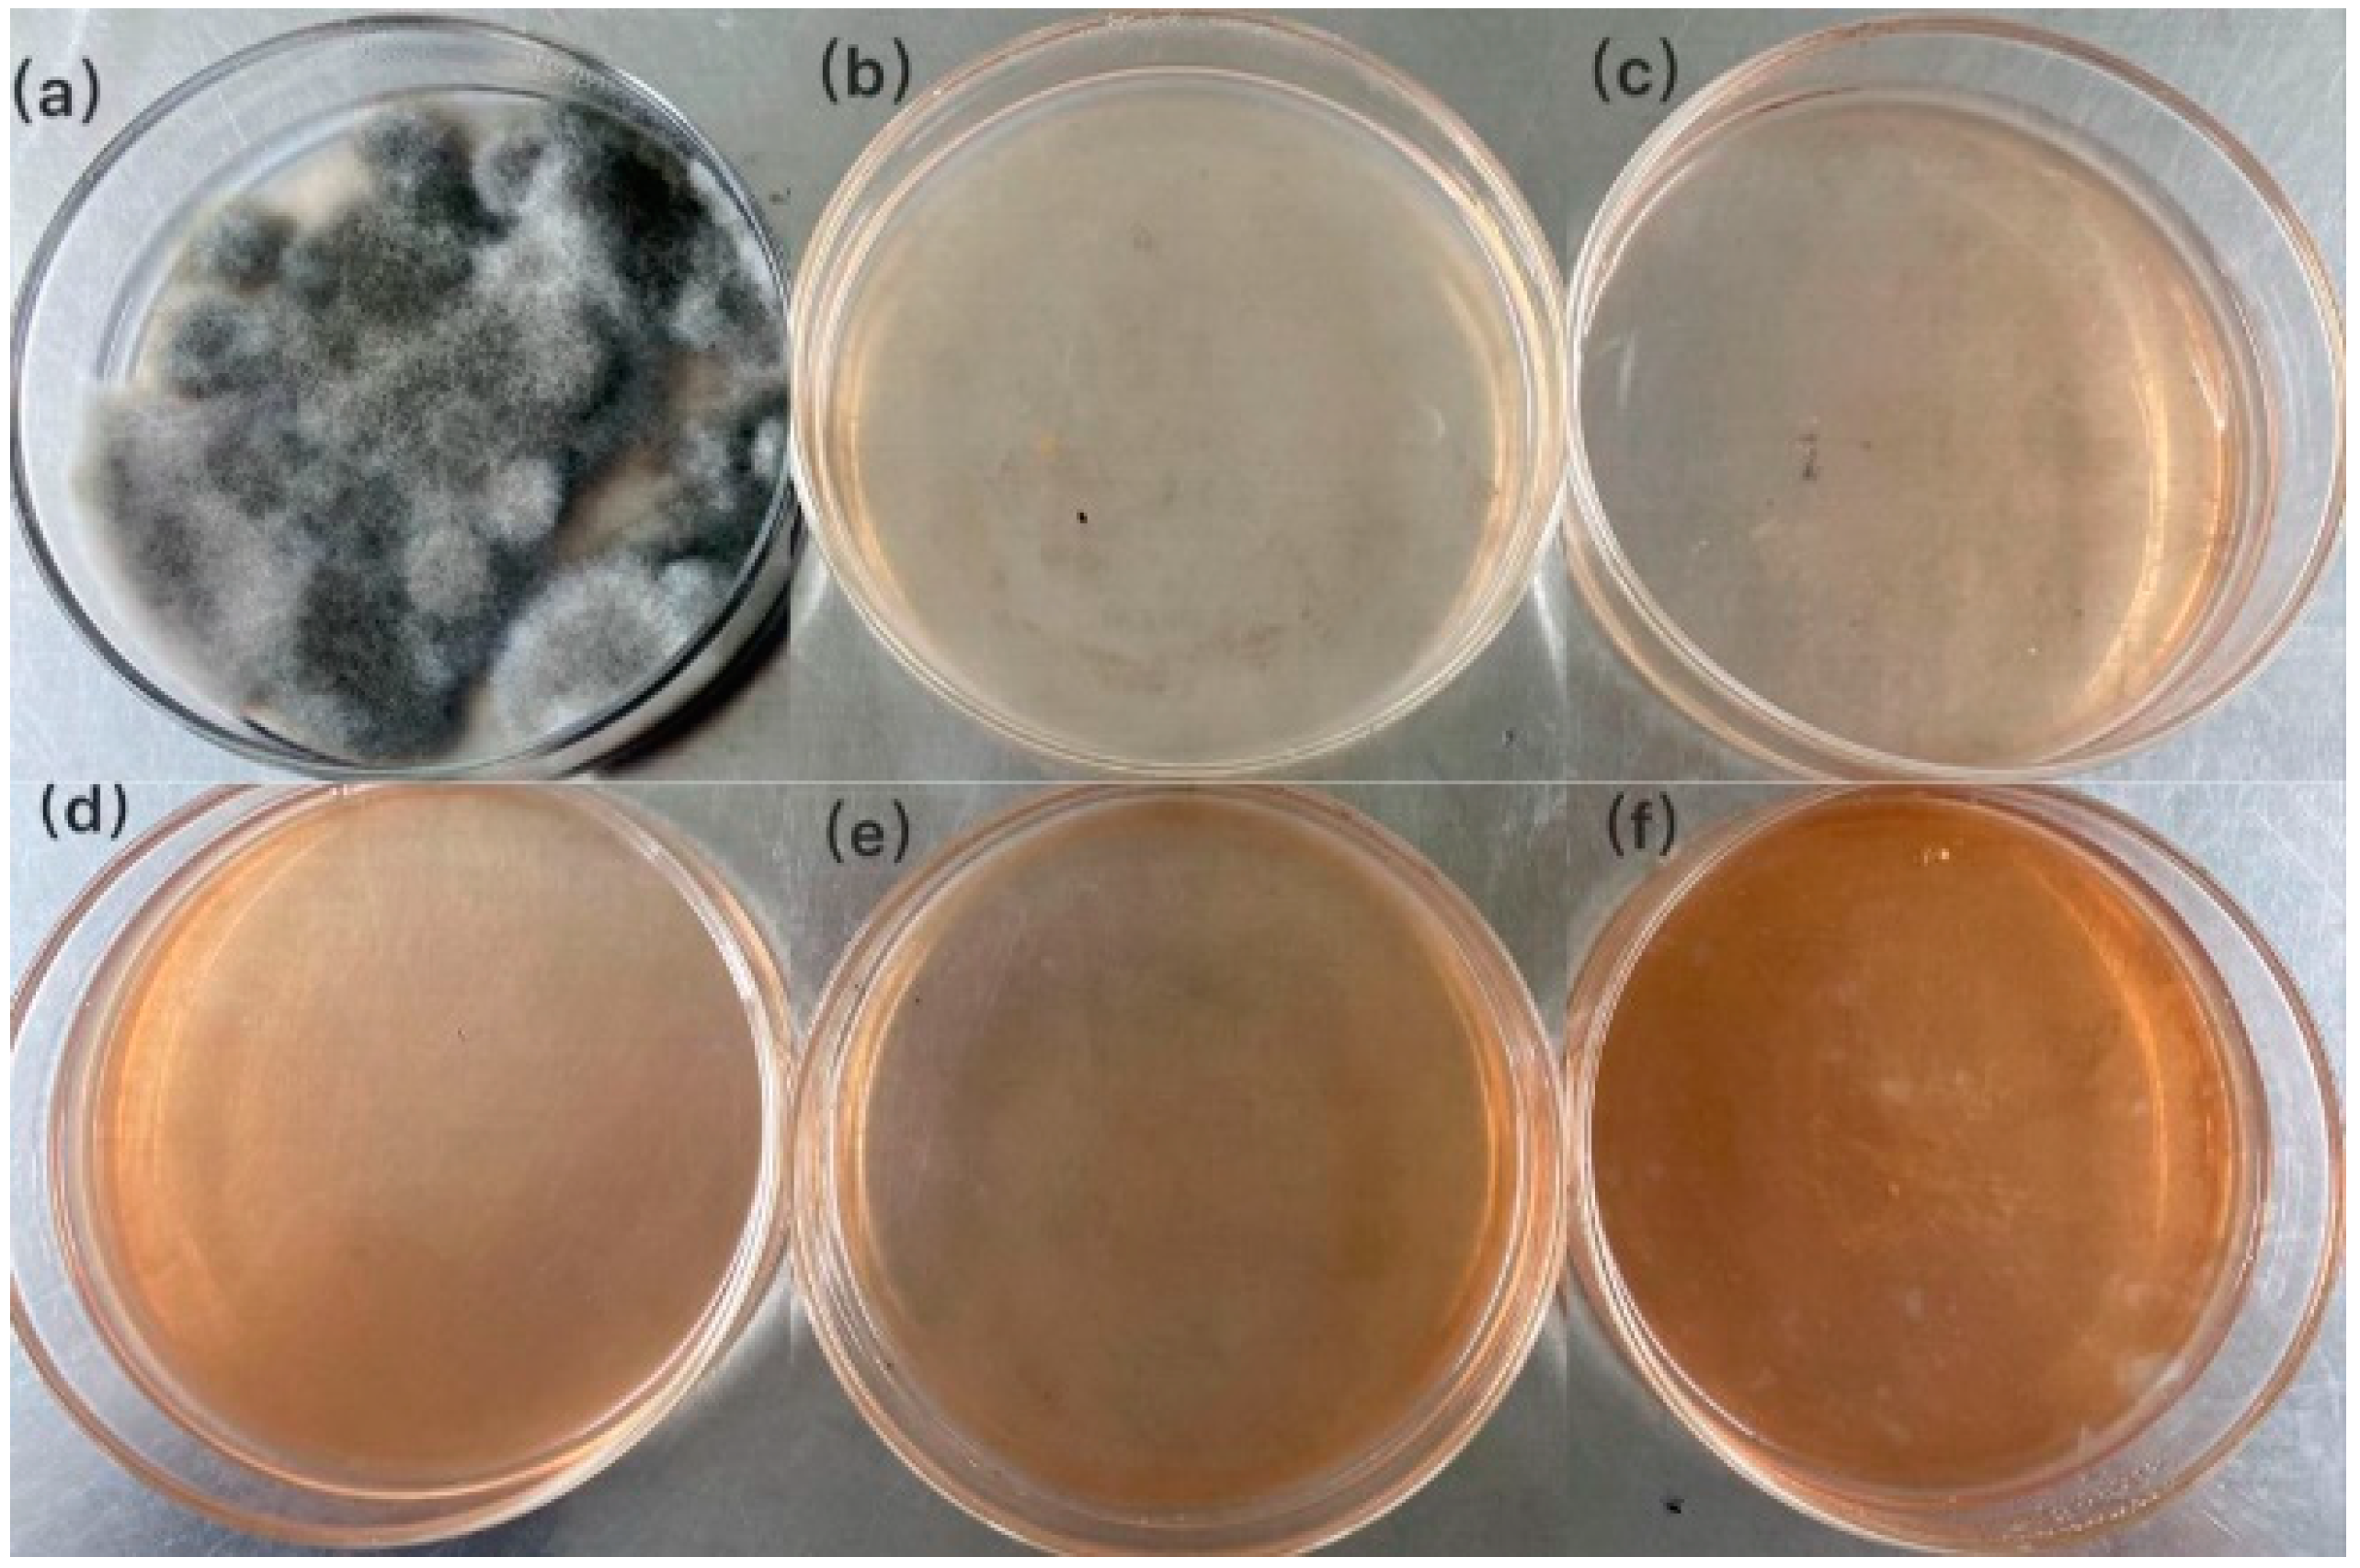
Crystals 11 01443 g006 Crystals 11 01443 g006

Biosynthesis of Silver Nanoparticles by Conyza canadensis and Their Antifungal Activity against Bipolaris maydis
Abstract
1. Introduction
2. Materials and Methods
2.1. Fungus Isolation and Plant Tissue
2.2. Biosynthesis of Silver Nanoparticles
2.3. Characterization of Silver Nanoparticles
2.4. Antifungal Activity of Silver Nanoparticles against B. maydis
2.4.1. Inhibition of Colony Growth
2.4.2. Influence on Colony Formation
2.4.3. Measurement of the Inhibition Zone
3. Results and Discussion
3.1. Biosynthesis of Silver Nanoparticles
3.2. TEM Analysis of Silver Nanoparticles
3.3. SEM Analysis of Silver Nanoparticles
3.4. XRD Analysis of Silver Nanoparticles
3.5. Inhibition of Colony Growth
3.6. Influence on Colony Formation
3.7. Inhibition Zone Diameter
4. Conclusions
Author Contributions
Funding
Institutional Review Board Statement
Informed Consent Statement
Data Availability Statement
Conflicts of Interest
References
- Sun, S.W.; Xu, L.; Zou, Q.; Wang, G.H. BP4RNAseq: A babysitter package for retrospective and newly generated RNA-seq data analyses using both alignment-based and alignment-free quantification method. Bioinformatics 2020, 37, 1319–1321. [Google Scholar] [CrossRef] [PubMed]
- Hou, C.; Yin, M.; Lan, P.; Wang, H.R.; Nie, H.; Ji, X.L. Recent progress in the research of Angelica sinensis (Oliv.) Diels polysaccharides: Extraction, purification, structure and bioactivities. Chem. Biol. Technol. Agric. 2021, 8, 13–26. [Google Scholar] [CrossRef]
- Ji, X.L.; Cheng, Y.Q.; Tian, J.Y.; Zhang, S.Q.; Jing, Y.S.; Shi, M.M. Structural characterization of polysaccharide from jujube (Ziziphus jujuba Mill.) fruit. Chem. Biol. Technol. Agric. 2021, 8, 54–60. [Google Scholar] [CrossRef]
- Osuwa, J.C.; Anusionwu, P.C. Some advances and prospects in nanotechnology: A review. Asian J. Inf. Technol. 2011, 10, 96–100. [Google Scholar] [CrossRef]
- Khademhosseini, A.; Parak, W.J.; Weiss, P.S. Nanoscience and Nanotechnology around the World. ACS Nano 2016, 10, 4883–4884. [Google Scholar] [CrossRef][Green Version]
- Li, H.; Wang, F. Core-shell chitosan microsphere with antimicrobial and vascularized functions for promoting skin wound healing. Mater. Design 2021, 204, 109683. [Google Scholar] [CrossRef]
- Zhao, L.; Wang, H.; Huo, K.; Cui, L.; Zhang, W.; Ni, H. Antibacterial nano-structured titania coating incorporated with silver nanoparticles. Biomaterials 2011, 32, 5706–5716. [Google Scholar] [CrossRef] [PubMed]
- Ren, Y.Y.; Yang, H.; Wang, T.; Wang, C. Green synthesis and antimicrobial activity of monodisperse silver nanoparticles synthesized using Ginkgo biloba leaf extract. Phys. Lett. A 2016, 380, 3773–3777. [Google Scholar] [CrossRef]
- Bakshi, M.; Singh, H.B.; Abhilash, P.C. The unseen impact of nanoparticles: More or less? Curr. Sci. 2014, 106, 350–352. [Google Scholar]
- Kumari, A.; Guliani, A.; Singla, R.; Yadav, R.; Yadav, S.K. Silver nanoparticles synthesized using plant extracts show strong antibacterial activity. IET Nanobiotechnol. 2015, 9, 142–152. [Google Scholar] [CrossRef]
- Huang, W.D.; Wang, C.J.; Duan, H.M.; Bi, Y.L.; Wu, D.G.; Du, J.L.; Yu, H.B. Synergistic Antifungal Effect of Biosynthesized Silver Nanoparticles Combined with Fungicides. Int. J. Agric. Biol. 2018, 20, 1225–1229. [Google Scholar]
- Wang, C.; Kim, Y.J.; Singh, P.; Mathiyalagan, R.; Jin, Y.; Yang, D.C. Green synthesis of silver nanoparticles by Bacillus methylotrophicus, and their antimicrobial activity. Artif. Cell Nanomed. B 2016, 44, 1127–1132. [Google Scholar]
- Huang, W.D.; Bao, Y.; Duan, H.M.; Bi, Y.L.; Yu, H.B. Antifungal effect of green synthesized silver nanoparticles against Setosphaeriaturcica. IET Nanobiotechnol. 2017, 11, 803–808. [Google Scholar] [CrossRef]
- Ho, C.H.; Odermatt, E.K.; Berndt, I.; Tiller, J.C. Long-term active antimicrobial coatings for surgical sutures based on silver nanoparticles and hyper branched polylysine. J. Biomat. Sci.-Polym. E 2013, 24, 1589–1600. [Google Scholar] [CrossRef]
- Li, W.R.; Xie, X.B.; Shi, Q.S.; Duan, S.S.; Ouyang, Y.S.; Chen, Y.B. Antibacterial effect of silver nanoparticles on Staphylococcus aureus. Biometals 2011, 24, 135–141. [Google Scholar] [CrossRef] [PubMed]
- Khatami, M.; Mehnipor, R.; Poor, M.H.S.; Jouzani, G.S. Facile Biosynthesis of Silver Nanoparticles Using Descurainia sophia and Evaluation of Their Antibacterial and Antifungal Properties. J. Clust. Sci. 2016, 27, 1601–1612. [Google Scholar] [CrossRef]
- Khatami, M.; Pourseyedi, S. Phoenix dactylifera (date palm) pit aqueous extract mediated novel route for synthesis high stable silver nanoparticles with high antifungal and antibacterial activity. IET Nanobiotechnol. 2015, 9, 184–190. [Google Scholar] [CrossRef]
- Narayanan, K.B.; Park, H.H. Antifungal activity of silver nanoparticles synthesized using turnip leaf extract (Brassica rapa L.) against wood rotting pathogens. Eur. J. Plant. Pathol. 2014, 140, 185–192. [Google Scholar] [CrossRef]
- Lu, L.; Sun, R.W.Y.; Chen, R.; Hui, C.K.; Ho, C.M.; Luk, J.M.; Lau, J.K.; Che, C.M. Silver nanoparticles inhibit hepatitis B virus replication. Antivir Ther. 2008, 13, 253–262. [Google Scholar]
- Lara, H.H.; Ayala-Nunez, N.V.; Ixtepan-Turrent, L.; Rodriguez-Padilla, C. Mode of antiviral action of silver nanoparticles against HIV-1. J. Nanobiotechnol. 2010, 8, 1–6. [Google Scholar] [CrossRef]
- Khalil, N.M.; El-Ghany, M.N.A.; Rodríguez-Couto, S. Antifungal and anti-mycotoxin effificacy of biogenic silver nanoparticles produced by Fusarium chlamydosporum and Penicillium chrysogenum at non-cytotoxic doses. Chemosphere 2019, 218, 477–486. [Google Scholar] [CrossRef]
- Huang, W.D.; Yan, M.H.; Duan, H.M.; Bi, Y.L.; Cheng, X.X.; Yu, H.B. Synergistic Antifungal Activity of Green Synthesized Silver Nanoparticles and Epoxiconazole against Setosphaeria turcica. J. Nanomater. 2020, 3, 1–7. [Google Scholar] [CrossRef]
- Hussain, I.; Singh, N.B.; Singh, A.; Singh, H.; Singh, S.C. Green synthesis of nanoparticles and its potential application. Biotechnol. Lett. 2016, 38, 545–560. [Google Scholar] [CrossRef]
- Albrecht, M.A.; Evan, C.W.; Raston, C.L. Green chemistry and the health implications of nanoparticles. Green Chem. 2006, 8, 417–432. [Google Scholar] [CrossRef]
- Roy, S.; Das, T.K. Plant mediated green synthesis of silver nanoparticles-a review. Int. J. Plant Biol. Res. 2015, 3, 1044–1054. [Google Scholar]
- Mittal, A.K.; Chisti, Y.; Banerjee, U.C. Synthesis of metallic nanoparticles using plant extracts. Biotechnol. Adv. 2013, 31, 346–356. [Google Scholar] [CrossRef]
- Song, J.Y.; Kim, B.S. Rapid biological synthesis of silver nanoparticles using plant leaf extracts. Bioproc. Biosyst. Eng. 2009, 32, 79–84. [Google Scholar] [CrossRef]
- Sathiya, C.K.; Akilandeswari, S. Fabrication and characterization of silver nanoparticles using Delonixelata leaf broth. Spectrochim. Acta A 2014, 128, 337–341. [Google Scholar] [CrossRef]
- Philip, D. Green synthesis of gold and silver nanoparticles using Hibiscus rosasinensis. Physica E Low Dimens. Syst. Nanostruct. 2010, 42, 1417–1424. [Google Scholar] [CrossRef]
- Elechiguerra, J.L.; Burt, J.L.; Morones, J.R. Interaction of silver nanoparticles with HIV-1. J. Nanobiotechnol. 2005, 3, 1–6. [Google Scholar] [CrossRef]
- Rai, M.; Yadav, A.; Gade, A. Silver nanoparticles as a new generation of antimicrobials. Biotechnol. Adv. 2009, 27, 76–83. [Google Scholar] [CrossRef]
- Nagajyothi, P.C.; Lee, K.D. Synthesis of plant-mediated silver nanoparticles using Dioscorea batatas rhizome extract and evaluation of their antimicrobial activities. J. Nanomater. 2011, 2011, 1–7. [Google Scholar] [CrossRef]
- Kaviyaa, S.; Santhanalakshmia, J.; Viswanathanb, B.; Muthumaryc, J.; Srinivasanc, K. Biosynthesis of silver nanoparticles using Citrus sinensis peel extract and its antibacterial activity. Spectrochim. Acta A 2011, 79, 594–598. [Google Scholar] [CrossRef]
- Khalil, M.M.H.; Ismail, E.H.; Baghdady, K.Z.E.; Mohamed, D. Green synthesis of silver nanoparticles using olive leaf extract and its antibacterial activity. Arab. J. Chem. 2014, 7, 1131–1139. [Google Scholar] [CrossRef]
- Kathiraven, T.; Sundaramanickam, A.; Shanmugam, N.; Balasubramanian, T. Green synthesis of silver nanoparticles using marine algae Caulerpa racemosa and their antibacterial activity against some human pathogens. Appl. Nanosci. 2014, 5, 499–504. [Google Scholar] [CrossRef]
- Waghmare, S.R.; Mulla, M.N.; Marathe, S.R.; Sonawane, K.D. Ecofriendly production of silver nanoparticles using Candida utilis and its mechanistic action against pathogenic microorganisms. Biotechnology 2015, 5, 33–38. [Google Scholar] [CrossRef]
- Sarsar, V.; Selwal, M.K.; Selwal, K.K. Biogenic synthesis, optimisation and antibacterial efficacy of extracellular silver nanoparticles using novel fungal isolate Aspergillus fumigatus MA. IET Nanobiotechnol. 2016, 10, 215–221. [Google Scholar] [CrossRef]
- Abboud, Y.; Saffaj, T.; Chagraoui, A.; El Bouari, A.; Brouzi, K.; Tanane, O.; Ihssane, B. Biosynthesis, characterization and antimicrobial activity of copper oxide nanoparticles (CONPs) produced using brown alga extract (Bifurcaria bifurcata). Appl. Nanosci. 2014, 4, 571–576. [Google Scholar] [CrossRef]
- Khatami, M.; Heli, H.; Jahani, P.M. Copper/copper oxide nanoparticles synthesis using Stachys lavandulifolia and its antibacterial activity. IET Nanobiotechnol. 2017, 11, 709–713. [Google Scholar] [CrossRef]

| Volume of Silver Nanoparticles (μL) | Inhibition Zone Diameter (mm) |
|---|---|
| 0 | 0.00 ± 0.00 |
| 20 | 7.00 ± 0.87 |
| 30 | 8.60 ± 2.05 |
| 40 | 11.20 ± 1.86 |
| 50 | 13.20 ± 1.12 |
Publisher’s Note: MDPI stays neutral with regard to jurisdictional claims in published maps and institutional affiliations. |
© 2021 by the authors. Licensee MDPI, Basel, Switzerland. This article is an open access article distributed under the terms and conditions of the Creative Commons Attribution (CC BY) license (https://creativecommons.org/licenses/by/4.0/).
Share and Cite
Yi, Y.; Wang, C.; Cheng, X.; Yi, K.; Huang, W.; Yu, H. Biosynthesis of Silver Nanoparticles by Conyza canadensis and Their Antifungal Activity against Bipolaris maydis. Crystals 2021, 11, 1443. https://doi.org/10.3390/cryst11121443
Yi Y, Wang C, Cheng X, Yi K, Huang W, Yu H. Biosynthesis of Silver Nanoparticles by Conyza canadensis and Their Antifungal Activity against Bipolaris maydis. Crystals. 2021; 11(12):1443. https://doi.org/10.3390/cryst11121443
Chicago/Turabian StyleYi, Yueming, Changjin Wang, Xinxin Cheng, Kechuan Yi, Weidong Huang, and Haibing Yu. 2021. "Biosynthesis of Silver Nanoparticles by Conyza canadensis and Their Antifungal Activity against Bipolaris maydis" Crystals 11, no. 12: 1443. https://doi.org/10.3390/cryst11121443
APA StyleYi, Y., Wang, C., Cheng, X., Yi, K., Huang, W., & Yu, H. (2021). Biosynthesis of Silver Nanoparticles by Conyza canadensis and Their Antifungal Activity against Bipolaris maydis. Crystals, 11(12), 1443. https://doi.org/10.3390/cryst11121443
